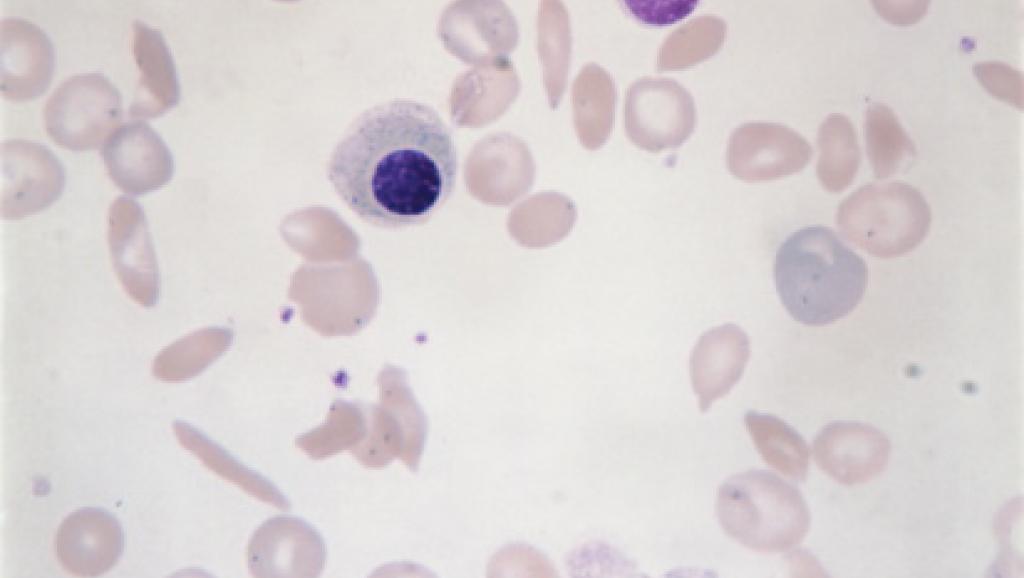

C'est une immense avancée dans le traitement de la drépanocytose, cette maladie génétique très répandue en Afrique et en Inde notamment. Le New England Journal of Medecine révèle que la thérapie génique a permis de traiter avec succès un premier patient, un adolescent de 13 ans greffé à Paris en octobre 2014.
Aujourd’hui, le jeune patient ayant bénéficié de ce nouveau traitement, ne souffre plus de crises très douloureuses, conséquences directes de la maladie. La drépanocytose est due à la mutation d’un gène touchant l’hémoglobine des globules rouges. Et la déformation des globules peut bloquer des vaisseaux sanguins entravant ainsi le transport de l’oxygène dans l’organisme.
Cette anomalie entraîne des lésions au cœur, dans les reins, les os, mais aussi au cerveau. Elle autorise encore une hyper sensibilité aux infections. Ce sont donc des cellules souches sanguines prélevées sur le malade et corrigées en laboratoire par un gène-médicament qui ont été réinjectées après l’élimination des cellules anormales de sa moelle osseuse.
Jusqu’à présent, seule une greffe de moelle osseuse pouvait remplacer la transfusion mensuelle et les médicaments antidouleur. Ces premiers résultats confirment l’efficacité de cette forme de thérapie, estiment les chercheurs, et offrent une véritable alternative aux plus de 5 millions de personnes concernées par la drépanocytose dans le monde d’origine africaine, antillaise et indienne.
Avec RFI





























Application de CComment' target='_blank'>CComment